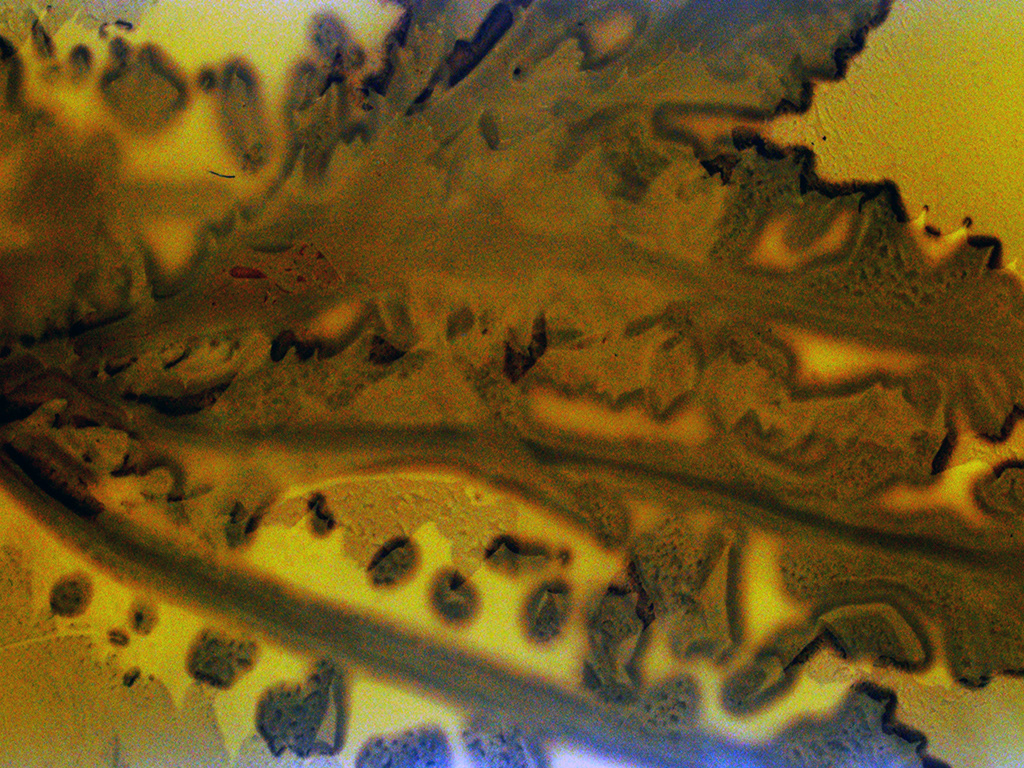

Text from Exhibition Catalogue:
Lullaby (An Acknowledgement of River Country) is a 35mm cameraless film exploring the captivating, but often overlooked world of the native Western Australian brown macroalgae species Sargassum sp. In situ observation of the rhythmic interplay of the Derbarl Yerrigan/Swan River’s semi-diurnal tide cycles throughout the six Noongar seasons, and its influence on Sargassum’s growth, behaviour, and reproductive patterns, govern the film’s overall visual aesthetics, sound, and structure.
Created over the course of twelve months, Sargassum was sustainably foraged and transformed into seven seconds of film each week, producing a cumulative 365-second cycle that mirrors both the solar year and the organism’s seasonal life rhythms. Each frame (365×24) unfolds as a phytogram: a photographic contact-printing technique where Sargassum is meticulously arranged on the photosensitive surface of reclaimed expired 35mm film and exposed to the sun. As the light-sensitive emulsion reacts with Sargassum’s internal photosynthetic chemistry, intricate details, textures, shapes, and colours alchemically embed themselves into the celluloid’s surface.
Lullaby also incorporates expired 35mm film immersed in Sargassum’s intertidal rockpool habitats for an entire solar year, along with film gently grattaged using sand, shells, and rocks found in its natural environment. Diverse expired 35mm film types highlight Sargassum’s seasonally transformative morphology. The film’s ethereal soundscape, drawn solely from Sargassum’s bio-rhythms (recorded with a bio-sonification device connected to a synthesiser during both winter and summer solstice), gives voice to its sentience, deepening viewers’ awareness of the (mostly) unseen contributions of seaweeds to human and ecological health and wellbeing.